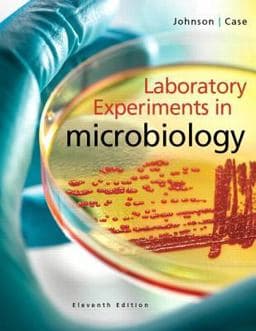
9780321994936

Laboratory Experiments in Microbiology
Format: Spiral-bound
ISBN13: 9780321994936
✨ Featured Offer
Brand New
$187.32
List Price: $139.20
FREE standard delivery by: 01 Apr 2026
Overview
For general microbiology laboratory courses.
Containing 57 thoroughly class-tested and easily customizable exercises, Laboratory Experiments in Microbiology, Eleventh Edition, provides engaging labs with instruction on performing basic microbiology techniques and applications for undergraduate students in diverse areas, including the biological sciences, allied health sciences, agriculture, environmental science, nutrition, pharmacy, and various pre-professional programs.
The perfect companion to Tortora/Funke/Case's Microbiology: An Introduction or any introductory microbiology text, the Eleventh Edition features fourteen new Part-opening Case Studiesthat introduce students to a real world scenario or health-oriented case that connects the lab exercises to an engaging, familiar context. Updates to the new ASM BSL-2 safety lab protocol enhance flexibility and customization options for the instructor. MasteringMicrobiology's newly updated prelab quizzes along with MicroLab Tutors and Lab Technique Videos ensure students arrive prepared for each lab and provide additional review opportunities.
| ISBN-13 | 9780321994936 |
|---|---|
| ISBN-10 | 0321994930 |
| Weight | 2.14 Pounds |
| Dimensions | 8.80 x 0.70 x 10.70 In |
| List Price | $139.20 |
| Edition | 11th Edition |
| Format | Spiral-bound |
|---|---|
| Language | English |
| Pages | 496 pages |
| Publisher | Pearson |
| Published On | 2015-01-09 |
View All Offers
Sort by:
Seller details
Dallas, TX, USA
Free delivery by: 01 Apr 2026
Seller details
Santa Clarita, CA, USA
Free delivery by: 01 Apr 2026
Seller details
Franklin Lakes, NJ, USA
Free delivery by: 01 Apr 2026
Seller details
Midland Park, NJ, USA
Free delivery by: 01 Apr 2026
Seller details
Santa Clarita, CA, USA
Free delivery by: 01 Apr 2026